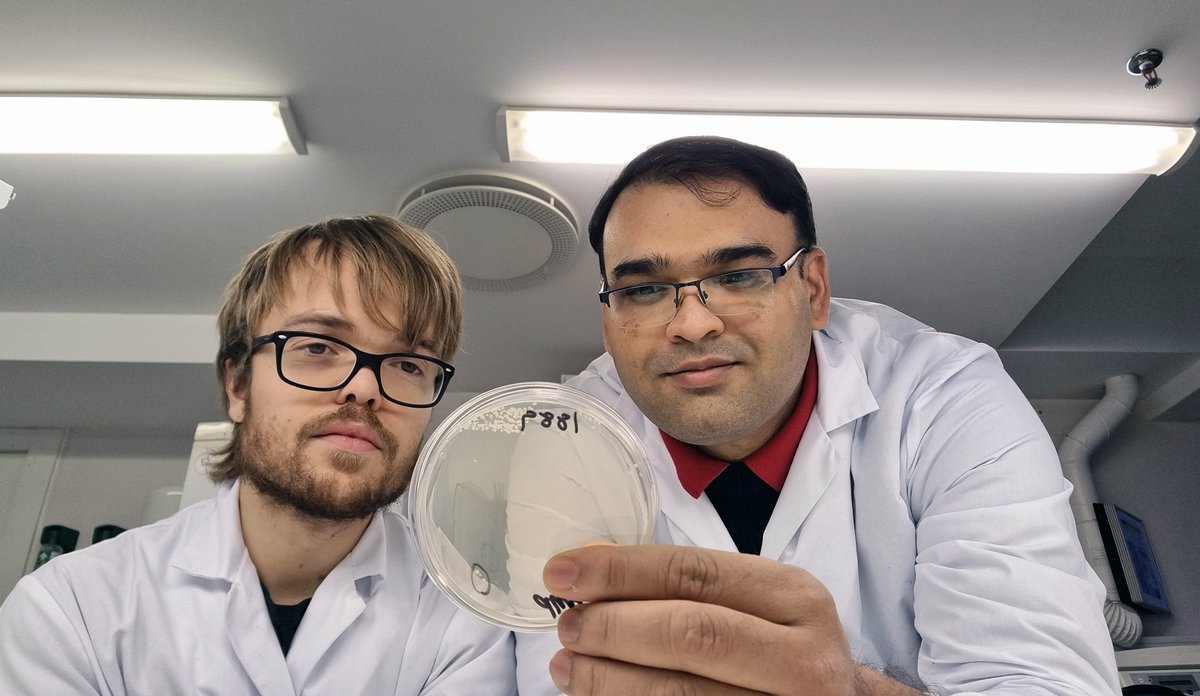
HI-forskere Didrik og Nachiket på laboratoriet

Dette fant vi i bergensbæsjen
Forskerne tok prøver ved innløpet og utløpet til de fem store renseanleggene i Bergen, og fant bakterier som var resistente.
Fotograf: Nachiket P. Marathe / HavforskningsinstituttetPublisert: 21.02.2022
For første gang har HI-forskere undersøkt E. coli-bakterier fra kloakken i en hel by, og sjekket om de fant resistens mot antibiotika.
– Vi fant bakterier som var antibiotikaresistente, og oppdaget to nye resistensgener som ikke er funnet i Norge før, sier forsker Didrik Hjertaker Grevskott.
Men totalt sett vister studien lav forekomst av resistens i Bergens befolkning.
– Funnene våre er på linje med det som tidligere er sett i E. coli-prøver tatt av pasienter ved norske sykehus, sier Grevskott.
Kloakken gir svar
Kloakk er en kjent kilde til spredning av antibiotikaresistens i miljøet. Resistente bakterier som stammer fra mennesker, skilles ut i avføring og kan fortsette videre til havet.
Derfor har Grevskott og forsker-kollegaene undersøkt prøver fra de fem store renseanleggene i Bergen. Ved hvert renseanlegg ble det tatt prøver ved innløpet, og ved utløpet.
På grunn av korona-pandemien var det lite turister i Bergen da prøvene ble tatt i 2020. Prøvene gir derfor et godt bilde av resistenssituasjonen i byens befolkning.
– 7,3 prosent av E. coli-bakteriene fra innløpsprøvene, og 5,3 prosent av E. coli-bakteriene fra utløpsprøvene var multiresistente. Det betyr at bakteriene har gener som gjør dem motstandsdyktige mot tre eller flere typer antibiotika, forklarer Grevskott.
Oppdaget to nye resistensgener
– Når andre antibiotika ikke virker, er det dette legene bruker. Det er et «siste utvei»-antibiotikum, sier HI-forsker Nachiket P. Marathe.
Resistensgenet som ble identifisert heter tet(X4), og det er tidligere funnet i 23 andre land. Men dette er første gang det er oppdaget i Norge.
Ikke så lenge etterpå fant forskerne et nytt resistensgen i en prøve, som heter blaNDM-6. Det gir resistens mot en annen type «siste utvei»-antibiotikum som kalles karbapenemer. Dette genet er heller ikke oppdaget i Norge før, men finnes i flere andre land.
Unik overvåkningsstudie
Norske sykehus sjekker kun prøver fra pasienter for antibiotikaresistens. Denne studien gir et bedre bilde av resistenssituasjonen i en lokal befolkning som helhet.
– Gjennom å overvåke status i befolkningen og miljøet kan vi bli bedre rustet mot resistente bakterier, som kan dukke opp på sykehus i fremtiden, forklarer Marathe.
Resistens mot antibiotika er en stor utfordring på verdensbasis, og viktig å følge med på også i Norge.
– Overvåkningsmetoden fra studien vår kan myndighetene ta i bruk når de skal utforme strategier for å hindre spredning av antibiotikaresistens i miljøet, sier han.
Referanse
Grevskott, D.H., Ghavidel, F.Z., Svanevik, C.S., Marathe, N.P. 2021. «Resistance profiles and diversity of β-lactamases in Escherichia coli strains isolated from city-scale sewage surveillance in Bergen, Norway mimic clinical prevalence». Ecotoxicology and Environmental Safety, 226, 112788. Lenke: https://doi.org/10.1016/j.ecoenv.2021.112788
